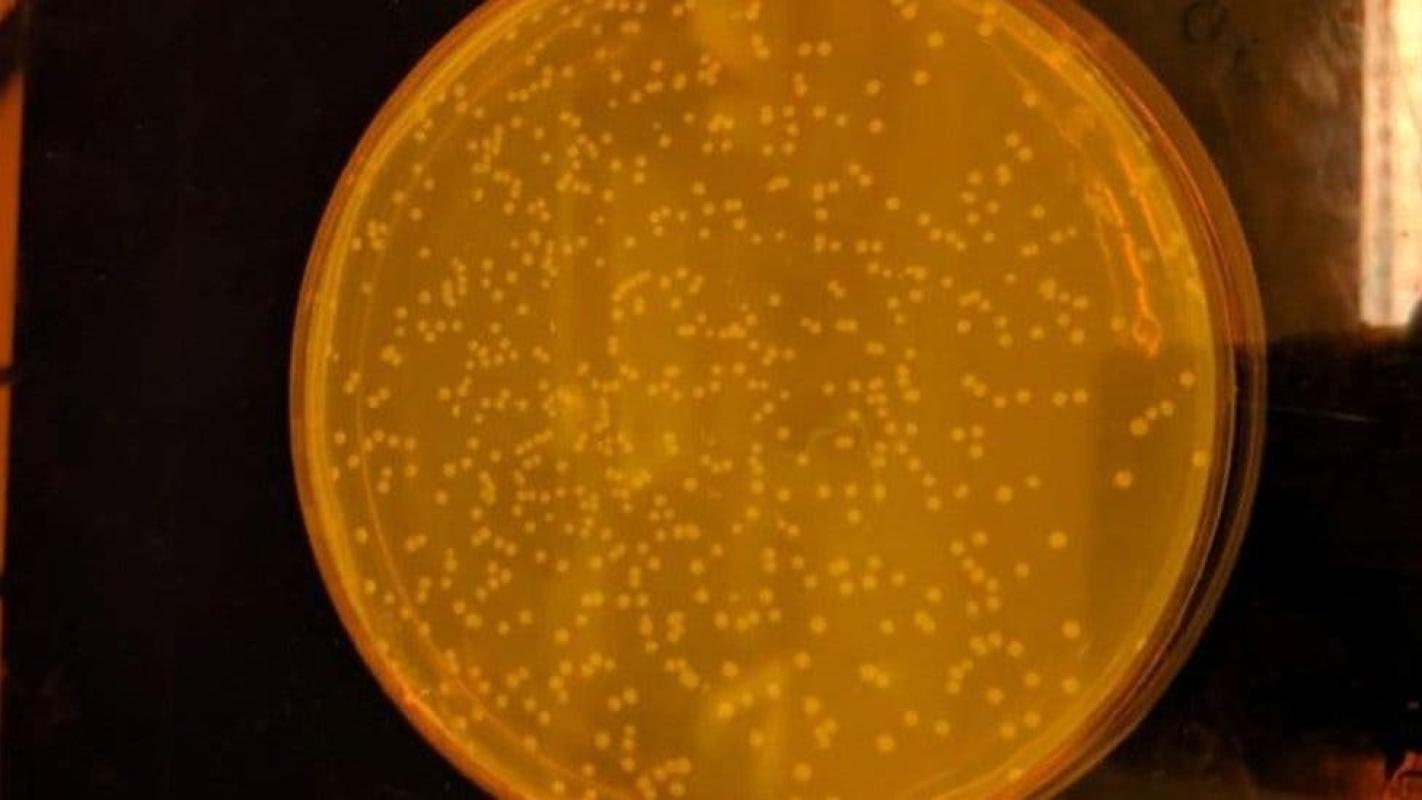

El primer organismo vivo creado por científicos con un ADN completamente sintético
El primer organismo vivo creado por científicos con un ADN completamente sintético
El primer organismo vivo creado por científicos con un ADN completamente sintético
T13 En Vivo
Un grupo de científicos de Cambridge, en Reino Unido, creó el primer organismo vivo del mundo con un código ADN completamente sintético.
La bacteria, denominada Syn61, es una versión artificial de la bacteria E. coli que vive en el intestino. Su código genético fue alterado y rediseñado significativamente.
El objetivo es que este organismo de ADN sintético allane el camino para las bacterias de diseño que podrían fabricar nuevos catalizadores, medicamentos, proteínas y materiales.
El hito científico fue aclamado por académicos y expertos en genética.
George Church, de la Universidad de Harvard, calificó la creación como un "descubrimiento importante", mientras que el profesor de biología sintética deL Imperial College, Tom Ellis, afirmó que el trabajo es "impresionante".
Cómo se creó
Las 4 millones de letras genéticas que contiene el Syn61 hacen de este el genoma completo más grande en ser sintetizado desde cero.
El trabajo de los ingenieros del genoma fue parecido al programa de mantenimiento de un ingeniero ferroviario, reemplazando el genoma de la bacteria E. coli por partes, sección por sección, en lugar de hacerlo todo de una vez. Así, las letras fueron ordenadas en segmentos cortos antes de ser ensambladas en longitudes de medio millón.
"El cromosoma bacteriano es muy grande", afirmó a la BBC el líder del equipo, Jason Chin. "Necesitábamos un enfoque que nos permitiera ver qué había fallado si hubiera habido errores en el camino", agregó.
Después de que cada segmento de medio millón de letras fuera probado en bacterias parcialmente sintéticas, los científicos unieron los ocho segmentos y crearon el organismo Syn61.
La estrategia fue más cautelosa que la utilizada por el bioempresario Craig Venter, quien en 2010 diseñó la bacteria parcialmente sintética Mycoplasma laboratorium basada en el pequeño organismo Mycoplasma genitalium.
"Ese fue un hito", recuerda Tom Ellis. Sin embargo, según el profesor de Imperial College, la investigación consumió durante muchos años los esfuerzos de un instituto creado, administrado y nombrado por Venter.
La nueva creación fue realizada por un pequeño equipo en el mundialmente famoso Laboratorio de Biología Molecular de Cambridge (LMB) y, según el doctor Chin, podría fácilmente ampliarse a genomas más grandes en cualquier laboratorio bien equipado.
En el proceso, el equipo liderado por Chin encontró solo cuatro errores en los cuatro millones de letras genéticas sintetizadas y se corrigieron fácilmente.
Genoma recodificado
Pero las ambiciones del doctor Chin van más allá de romper los récord de cromosomas.
El nuevo genoma también ha sido recodificado. Este es un primer paso para permitirle a los biólogos sintéticos incorporar componentes en biomoléculas que no existen en la naturaleza.
El código del ADN contiene instrucciones para la célula sobre cómo ensamblar proteínas, las biomoléculas primarias de un cuerpo. Así como el ADN está compuesto de cadenas de elementos de ácido nucleico único, las proteínas están hechas de cadenas de aminoácidos simples.
La naturaleza tiene una paleta de 20 aminoácidos, como los denominados serina, leucina y alanina, entre otros. Su química dicta las propiedades de la proteína que producen, desde el cabello hasta las proteínas musculares y las enzimas del estómago.
Pero aunque la naturaleza solo se basa en 20, el código de ADN podría alojar hasta 64. El biólogo Francis Crick, quien trabajó en la investigación de LMB desde sus inicios, calificó esto como un "accidente congelado".
Como resultado, muchas de las "palabras" o codones del ADN conducen al mismo aminoácido. Hay seis formas, por ejemplo, de escribir las instrucciones para el aminoácido llamado serina, que Chin considera un desperdicio.
"Hemos eliminado algunas de las duplicaciones en el código natural para hacerlo más eficiente", explica uno de los colegas de Chin, Julius Fredens, quien supervisó gran parte del trabajo detallado en el laboratorio.
"Esta fue una transformación realmente radical", explica Chin.
Y aunque esto puede sonar como un nuevo mundo molecular, el doctor Chin dice que no debemos estar asustados.
"La gente tiene preocupaciones legítimas", dice. "Todo lo que inventamos tiene un doble uso. Pero lo importante es que tenemos un debate sobre lo que debemos y no debemos hacer. Y que estos experimentos se realizan de manera bien controlada", afirmó.








